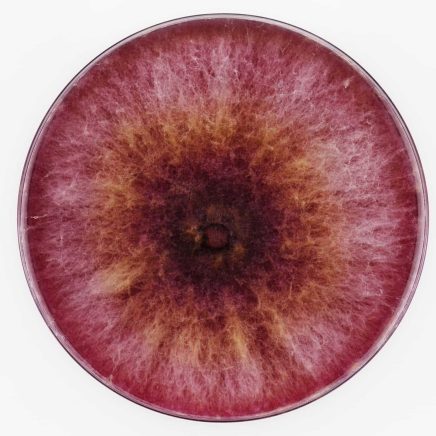

L is for Look Children’s Photobooks
In the ever-expanding historiography of photobook culture and history, once we escape the tedium of nationalism embedded in the ceaseless photobooks from “X” country, we can finally begin to untie genre, and to make sense of what attitudes that exceed these nationalistic behaviors have been present in the making of books throughout the 20th and […]